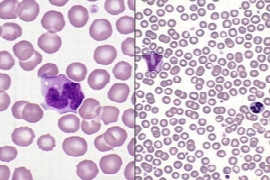

Camil Stoian
DVM, Ph.D, Dipl. EVDC

Camil Stoian
DVM, Ph.D, Dipl. EVDC
Österreichs einziger Spezialist / Internationaler Fachtierarzt auf dem Gebiet der Zahnmedizin der Kleintiere. DDr. Camil Stoian ist ein doppelt approbierter Zahn- und Tierarzt und einer der wenigen europäischen Tierzahnarztspezialisten. Er bietet mehr als 16 Jahre Erfahrung auf dem Gebiet der Tier-Zahnmedizin für Behandlung und Therapie von Mund-, Kiefer- und Gesichts Krankheiten. DDr. Stoian hat zahlreiche Workshops, Seminare und Vorträge in der ganzen Welt auf dem Gebiet der Tierzahnheilkunde abgehalten. Ausbildung
- Seit Jänner 2007: Diplomate of the European Veterinary Dental College, europäischer veterinärmedizinischer Zahnfacharzt
- Okt. 02- Jän. 07: Resident EVDC Ausbildung; Veterinärmedizinische Universität Wien, Klinik für Chirurgie, Augenheilkunde und Zahnheilkunde, Zahnstation, Österreich
- Okt. 99 – Okt. 05: Universität für landwirtschaftliche Wissenschaften, Cluj, Rumänien, Fakultät für Veterinärmedizin; Department für Chirurgie, Promotion zum: Doktor der Wissenschaften (Ph.D), Thema der wissenschaftlichen Arbeit: “Personal Research in Dental Implants in Dogs”
- Oktober 2002: Promotion zum Doktor der Zahnmedizin (Dr. med. dent.); Thema der Dissertation: “The Antibiotic Susceptibility and Resistance of some Species of Streptococci Isolated from the Oral Cavity”
- Okt. 96 – Sept. 02: Iuliu Hatieganu Universität für Human Medizin und Pharmazie, Cluj, Rumänien, Fakultät für Zahnheilkunde
- Oktober 1990: Promotion zum: Doktor der Veterinärmedizin (Dr. med. vet.), Thema der Dissertation: “Morphological Characteristics of “Mangalitza” Swine, and the Necessity to Preserve this Rare Breed as a Genetic Reserve”
- Sept. 85 – Sept. 90: Universität für landwirtschaftliche Wissenschaften, Cluj, Rumänien, Fakultät für Veterinärmedizin
Webinare

Camil Stoian
DMD, DVM, PhD, Diplomate EVDC

Camil Stoian
DMD, DVM, PhD, Diplomate EVDC
Dr. Stoian received both his veterinary(DVM) and human dental degree (DMD) from the University of Veterinary Medicine and Human Dental Medicine in Cluj-Napoca, Romania as well as his Ph.D. from the Surgery Department of the Veterinary Medicine Faculty in Cluj-Napoca with the Title “Personal research of Dental implants in Dogs”.
He worked 5 years at the Faculty of Medicine (Human) of the University of British Columbia in Vancouver, Canada managing an Animal Research Facility. Soon after graduating Dental Medicine he began a 3-year residency program with Prof. Dr. Karl Zetner, the pioneer of veterinary dentistry in Europe.
Since 2007 he is a European Veterinary Dentistry Specialist (Diplomate EVDC) and is presently running the Veterinary Dental Center in Vienna, Austria
Main author of 2 Veterinary Dental Books also published the first book of this specialty in Romania, author of over 40 publications in Austria and abroad. Dr. Stoian is a world recognized lecturer, his area of expertise spread in over 15 countries all over the world including USA, Trinidad and Tobago, Thailand, Germany, Romania, Turkey, Bulgaria, Hungary, Portugal, etc. in 4 different languages (German, English, Hungarian, Romanian).
His main areas of interest within veterinary dentistry are with Orthodontics, Maxillo-facial surgery and reconstruction as well as osteo-inductive and conductive material research.
Webinare

Camilla Edwards
DVM, CertAVP

Camilla Edwards
DVM, CertAVP
Dr. Camilla Edwards is passionate about first opinion level small animal veterinary ultrasound. She travels with her dog Pippi (a Nova Scotia Duck Tolling Retriever) within 50 miles of Cambridge as a peripatetic veterinary ultrasonographer, Camilla teaches ultrasound with Celtic SMR, Clarius and FOVU and has built a thriving Facebook community for First Opinion Small Animal Vets.
Through her website, www.fovu.co.uk, she reviews ultrasound machines with general practice small animal vets in mind. Camilla qualified as a vet in 2006 and has worked all over East Anglia, UK. Camilla is experienced in emergency and critical care, having gained her CertAVP in
2018.
Webinare

Carina Strohmayer
DVM, DipECVDI

Carina Strohmayer
DVM, DipECVDI
2004 - 2010 Studium der Veterinärmedizin Vetmeduni (Wien)
2008 4 Monate Klinische Rotation an der Washington State University (USA)
2010 - 2017 Doktoratsstudium der Veterinärmedizin, Vetmeduni (Wien)
2015 - 2018 Small Animal Residency Programme of the European College of Diagnostic Imaging, Vetmeduni (Wien). Jeweils ein Monat am Tierspital Zürich; Royal Veterinary College, London; North Carolina State University, USA
2019 - 2022 PhD Programm “Equine and feline oronasal papillomavirus positive and negative squamous cell carcinoma - a comparative study on the basis of diagnostic imaging, pathomorphologic and molecular methods.” Vetmeduni (Wien)
Seit 2023 PostDoc-Assistent:in mit QV-Option auf eine Laufbahnstelle , Vetmeduni (Wien) - Co-supervisor “One Health” PhD Projekt (Vetmeduni) “New theranostics targeting multidrug resistance in cancer”
Webinare

Carl Muhlnickel
DVM, BVSc., MANZCVS

Carl Muhlnickel
DVM, BVSc., MANZCVS
After graduation, Carl began his working life in small animal practice in the south eastern suburbs of Melbourne. He was accepted as an Intern in Small Animal Medicine at the University of Melbourne, where he was exposed to the breadth of veterinary practice, which encouraged him to pursue a career in Veterinary Pathology. Carl was then lucky enough to secure a residency position in the Central Veterinary Diagnostic Laboratory in Melbourne, Australia in 1998, with subsequent successful completion of Membership of the Australian College of Veterinary Science in Veterinary Pathology.
To this day, he has remained in laboratory practice serving the veterinary community, predominantly in Melbourne, as a dedicated and conscientious Veterinary Clinical Pathologist.
Webinare

Carla Appelgrein
DVM, BVSc, MANZCVS, GradDipEd, MVetClinStud, MVetSurg, DipECVS

Carla Appelgrein
DVM, BVSc, MANZCVS, GradDipEd, MVetClinStud, MVetSurg, DipECVS
Carla graduated from the University of Pretoria (South Africa) in 2010 and worked in small animal practice for several years in Port Lincoln Australia. She attained Membership of the Australian & New Zealand College in Small Animal Surgery by examination in 2014. In 2015, Carla completed a 12-month surgical teaching and research program at Murdoch University and in 2016 she commenced a 3-year specialist residency training program in Small Animal Surgery as well as Clinical and Research Masters degrees which she completed in 2018. In 2020, she became a Diplomat of the European College of Veterinary Surgeons by examination and is a registered specialist in Small Animal Surgery.
Webinare

Carolin Ehrmann
DVM, FTÄ für Pferde

Carolin Ehrmann
DVM, FTÄ für Pferde
Seit 04/2016: Klinik für Pferde, Innere Medizin, Justus-Liebig-Universität (JLU) Gießen
09/2015: Fachtierärztin für Pferde
05/2014 – 03/2016: Fachberatung Pferd Labor synlab.vet GmbH, Augsburg
05/2012: Dissertation „Gesamtgenomscan bei nicht verwandten Warmblutpferden mit COB“
04/2012 – 04/2014: Leiterin der Inneren Medizin, Pferdeklinik Burg Müggenhausen GmbH, Weilerswist 05/2007 – 03/2012: Assistentin an der Klinik für Pferde der JLU Gießen
04/2006 – 03/2007: Internship Pferd an der Klinik für Pferde der JLU Gießen
10/2000 – 02/2006: Studium der Tiermedizin an der JLU Gießen
Webinare

Caroline Kaiser
RVN, AVNAT, GradCertEdu

Caroline Kaiser
RVN, AVNAT, GradCertEdu
I began nursing in a mixed practice in a country clinic in NSW where I completed my Cert IV Veterinary Nursing. After five years I moved to Brisbane for a specialised nursing role which included surgery, oncology, intensive care and anaesthesia. After four great years, I headed to Singapore to gain international experience, then returned to Melbourne, Australia to work in a specialist hospital and from there I moved to Perth. There I completed a veterinary traineeship in anaesthesia and analgesia at Murdoch University where I remained working as an anaesthesia technician until December 2022. In 2018 I also gained my Graduate Certificate in Tertiary and Adult Education and am now completing my Masters in Education through research at Murdoch University. I deliver anaesthesia workshops, lectures, and clinical training to graduated nurses through my new venture ‘Atomic Anaesthesia’ and remain extremely committed to increasing the quality of continuing education for Australian veterinary nurses and technicians. In 2023 I moved to London with my husband and daughter and began working in a progressive small animal first opinion practice. I have a Rhodesian Ridgeback called Roger and a rescue cat called Maple, who both made the big trip from Australia!
Webinare

Carolyn O’Brien
DVM, BVSc(Hons), MVetClinStud, FACVSc (feline)

Carolyn O’Brien
DVM, BVSc(Hons), MVetClinStud, FACVSc (feline)
She graduated from the University of Melbourne and worked in private practice both in Melbourne and the UK for the first five years of her veterinary career. Carolyn then completed a residency in Small Animal Medicine at the University of Sydney. She concurrently obtained a Masters in Veterinary Clinical Studies in the epidemiology and treatment of cryptococcosis in cats and dogs. After her residency she stayed on at the University of Sydney as a Senior Registrar.
Having successfully gained her fellowship qualification, she commenced referral practice in Melbourne, from the Veterinary Referral Hospital in Hallam and then from the University of Melbourne, as well as being a partner in a private feline-only clinic.
She is currently in the final stages of her PhD project, and is a senior tutor for the Centre of Veterinary Education’s Feline Medicine Distance Education course.
Carolyn is interested in all aspects of feline medicine but is particularly interested in infectious diseases and clinical microbiology. She also has a strong interest effective adult learning and professional development.
Webinare

Cat Walker
RVN, AMDRAS, Cert IV V.N., GradCert (Mental Health & Neuroscience), LLB, GradDip (Legal Practice), BA(Hons) (IntSt)

Cat Walker
RVN, AMDRAS, Cert IV V.N., GradCert (Mental Health & Neuroscience), LLB, GradDip (Legal Practice), BA(Hons) (IntSt)
Cat Walker is a Veterinary Mediator & Conflict Coach, Registered Veterinary Nurse, Lawyer, and Associate Lecturer at the University of Queensland’s School of Veterinary Science. With extensive experience spanning clinical practice and practice management, Cat has successfully owned and managed both general practice and emergency hospitals. She is the founding director of Vet Complaints Support, helping clinics manage and reduce client complaints. Cat also provides veterinary mediation and conflict coaching services and is a published author on clinical communication. She uses neuroscience‑informed, evidence‑based strategies to improve patient outcomes, client experience and team wellbeing.
Webinare

Cat Williams
DVM, DACVIM (Cardiology)

Cat Williams
DVM, DACVIM (Cardiology)
Cat is a graduate of the Mississippi State University College of Veterinary Medicine and completed her internship and residency in internal medicine and cardiology at California Animal Hospital. After becoming a board-certified cardiologist, she worked at several practices in Nevada, Pasadena, and Los Angeles. Cat frequently collaborates with human doctors from UCLA to work toward the most up-to-date treatment plans for her patients and is the only person in the world to implant a pacemaker in a rabbit. Cat is also a Clinical Associate Professor for Western University of Health Sciences and has published articles in the journal of the SCVMA. Cat's professional interests include managing chronic cardiology cases as well as interventional cardiology, a cutting-edge subset of medicine that allows for minimally invasive procedures for her patients. Outside of the hospital, Cat loves being outdoors! She really enjoys yoga, hiking, surfing, snowboarding, and meditation. Keeping in line with her professional passion, she also collects hearts-Cat has a Facebook page dedicated to photos of heart-shaped objects like leaves, shadows, flowers, and more!
Webinare

Catharina Lücking
DVM

Catharina Lücking
DVM
Catharina Lücking hat nach ihrem Abitur Veterinärmedizin an der Universität Giessen studiert. Im Anschluss an das Staatsexamen arbeitete sie 15 Monate als Tierärztin im Rahmen eines Internships in der Kleintierklinik der Universität Giessen. Seit 2014 arbeitet sie bei Royal Canin zunächst im Außendienst und seit 2018 als Scientific Trainer.
Webinare

Catherine Chan
DVM, CHAN BVSC (HONS I), FANZCVS (Veterinary Oncology)

Catherine Chan
DVM, CHAN BVSC (HONS I), FANZCVS (Veterinary Oncology)
Catherine is a Veterinary Oncologist based in Brisbane, Australia. After graduation in 2009, Catherine completed an internship and worked in both emergency and general practice, before moving to Sydney in 2012 to complete a three-year residency in Veterinary Oncology. Catherine has also spent time in the USA at the University of Missouri and Colorado State University. She has completed both her American (ACVIM) and Australian (ANZCVS) Veterinary Oncology training. Catherine is currently the director and consultant for an online Veterinary Oncology Consultancy Service ‘The Pet Oncologist’, where she provides veterinarians worldwide remote pet cancer advice and support. She also consults with pet owners directly one day a week at Veterinary Specialists in Underwood. In her spare time, she likes to spend time with her two little boys and sometimes she likes to spend time with her husband and cat.
Webinare

Catheryn Walsh
DVM, BSc, BVSc (Hons), MANZCVS (Radiology), Grad Cert (Hons) (Abdominal Ultrasound)

Catheryn Walsh
DVM, BSc, BVSc (Hons), MANZCVS (Radiology), Grad Cert (Hons) (Abdominal Ultrasound)
Dr Catheryn has worked in general practice for 12 years. She received a membership in diagnostic imaging in 2018, has a special interest in internal medicine, and a graduate certificate in abdominal ultrasound. She is currently undertaking post graduate study in cardiology. She runs her own mobile ultrasound business and analyses radiographs for other vets on a regular basis.
Webinare

Cathy Warburton
DVM, BSc, BVMS, MACVSc, MVS, TAA, Dip Pos Psych and Well-being

Cathy Warburton
DVM, BSc, BVMS, MACVSc, MVS, TAA, Dip Pos Psych and Well-being
Cathy is a veterinarian who worked as a clinician, trainer and manager in private, university and corporate practices for 25 years before realigning to work solely in the area of veterinary well-being. She is the owner of Make Headway, a business providing training, coaching and support programs to enhance the non-technical competencies (or “soft skills”) of the veterinary industry. Cathy is committed to advancing veterinary mental health and well-being. And she makes sure she walks the walk as well as talking the talk.